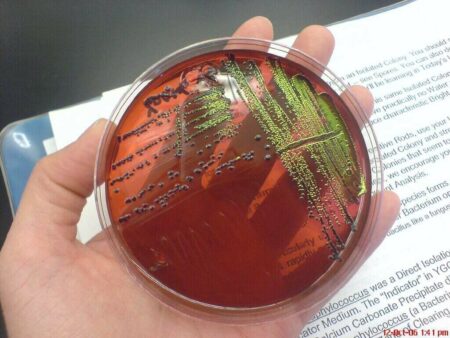
CDC Warns of E. Coli Outbreak CDC

An urgent message from the Centers for Disease Control and Prevention (CDC) said that 29 people in Michigan and Ohio were sickened by Escherichia coli, and nine were hospitalized. However, no deaths have been reported. The CDC said the source of infection had not been identified in this outbreak.
What is E. Coli?
E. coli bacteria are found in food items, the environment, and the guts of humans and animals. While Pathogenic E. coli (ETEC) causes urinary tract, pneumonia, and respiratory infections, most E. coli (EC) strains are harmless and play an essential role in maintaining intestinal health. These E. coli produce Shiga toxins, killing red blood cells and causing kidney failure. E. coli-induced toxins are responsible for about 265,000 U.S. deaths annually and about 30 deaths annually.
A person becomes infected with E. coli by swallowing a tiny amount of animal or human feces, usually invisible. An incubation period of three to four days is standard, but it can be as short as one day or as long as 10 days. Contaminated food or water is the usual way for people to become infected. While most people have some risk of being infected, the CDC says, it can be transmitted between people and from animals to people.
CDC Mentions E. Coli Symptoms
The CDC mentions E. coli symptoms such as diarrhea, excessive vomiting, and dehydration. Some E. coli types cause stomach cramps and bloody stools. Fever, among other symptoms, is also common. Severe cases are potentially lethal. It can be dangerous if a person has diarrhea that lasts more than three days, if stools are bloody, or if diarrhea is accompanied by a fever over 102˚F. In addition, people should see their doctor if they are vomiting and can’t keep liquids down or pass little urine.
Is there a Vaccine or Treatment for E. Coli Illness?
It is possible to recover from an E. coli infection. However, these infections may lead to severe and possibly deadly complications in people with weakened immune systems, pregnant individuals, young children, and senior citizens. Those with an E. coli infection may recover fully.
E. coli outbreaks have been associated with nursery schools, hotels, and swimming pools worldwide, resulting in temporary closures. CDC is now handling the investigation of multistate E. coli outbreaks.
CDC Encourages Proper Food Safety
CDC encourages people to practice proper food safety by rinsing fruits and vegetables. Wash utensils and surfaces often, keeping raw meat separate from other foods. Use a food thermometer to ensure the meat is cooked thoroughly, and refrigerate perishable items. Do not swallow water while swimming. Lakes, ponds, swimming pools, and streams should be avoided. Raw milk, unpasteurized dairy products, and unpasteurized juices are all off-limits, as are unpasteurized milk and juice. After going to the toilet, changing diapers, and taking animals and their environments, including zoos and farms, hands should be thoroughly cleaned.
Is E. Coli Contagious?
E. coli can spread between people or animals and from person to person. It is commonly contracted by eating contaminated food or water. People working in a daycare center are at increased risk of spreading the bacteria to people during incubation. Symptoms usually resolve in 5 to 7 days, but they can last from 1 to 10 days.
When to See a Doctor?
Intestinal infection may lead to dehydration and life-threatening complications without treatment. Therefore, people with diarrhea, fever, and abdominal pain should seek emergency medical care. In addition, individuals who traveled to a foreign country and recently returned with intestinal infection symptoms feel dizzy or are becoming dehydrated must call their doctor immediately.
Treating E. Coli Infection
Most people with intestinal E. coli infections may treat their symptoms at home. Symptoms are typically gone in a few days to a week. Self-care tips include:
If someone has bloody diarrhea or a fever, speak with a doctor before taking over-the-counter (OTC) antidiarrheal medicines. Doctors don’t typically prescribe antibiotics to treat E. coli. Antibiotic resistance and dangerous side effects are among the reasons why. A physician may order hospitalization and intravenous fluids if dehydration is a problem. Most patients recover in 5 to 7 days after their symptoms subside.
Written by Janet Grace Ortigas
Edited by Cathy Milne-Ware
Sources:
The Washington Post: What to know about E. coli symptoms and how to prevent infection; by Jennifer Hassan
Healthline: Everything You Need to Know About E. Coli Infection; by Christine Case-Lo and Medically Reviewed by Modern Weng, D.O.
CDC: Prevention | E. coli
Featured and Top photo by Maxim Malov Courtesy of CDC Global’s Flickr Page – Creative Commons License
Inset Image Courtesy of Wearn‘s Flickr Page – Creative Commons License
Discover more from Guardian Liberty Voice
Subscribe to get the latest posts sent to your email.


